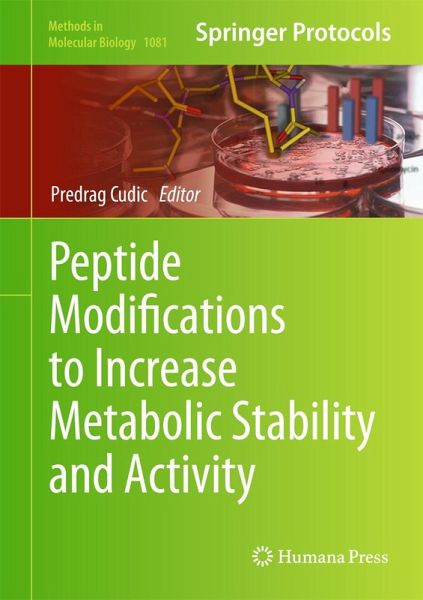

Peptide Modifications to Increase Metabolic Stability and Activity
PAYBACK Punkte
38 °P sammeln!
In Peptide Modifications to Increase Metabolic Stability and Activity, expert researchers in the field provide summarized methods for preparation, purification of modified peptides, and assessment of their biochemical activities. These methods and protocols include preparation of conformationally constrained peptides, modification of peptide bonds, introduction of nonproteinogenic amino acids, and alteration of peptides' physical and biological properties by modification of the amino acid side chains and/or terminal residues. With additional chapter that describes new experimental approach for...
In Peptide Modifications to Increase Metabolic Stability and Activity, expert researchers in the field provide summarized methods for preparation, purification of modified peptides, and assessment of their biochemical activities. These methods and protocols include preparation of conformationally constrained peptides, modification of peptide bonds, introduction of nonproteinogenic amino acids, and alteration of peptides' physical and biological properties by modification of the amino acid side chains and/or terminal residues. With additional chapter that describes new experimental approach for the detection of exogenous peptides within living cells using peptides labeled with heavy isotopes and confocal Raman microscopy. Written in the highly successful Methods in Molecular Biology series format, chapters include introductions to their respective topics, lists of the necessary materials and reagents, step-by-step, readily reproducible laboratory protocols, and tips on troubleshooting and avoiding known pitfalls.
Authoritative and practical, Peptide Modifications to Increase Metabolic Stability and Activity seeks to provide scientists with alternative approaches to peptide modification that many researchers may find applicable to their specific research requirements.
Authoritative and practical, Peptide Modifications to Increase Metabolic Stability and Activity seeks to provide scientists with alternative approaches to peptide modification that many researchers may find applicable to their specific research requirements.